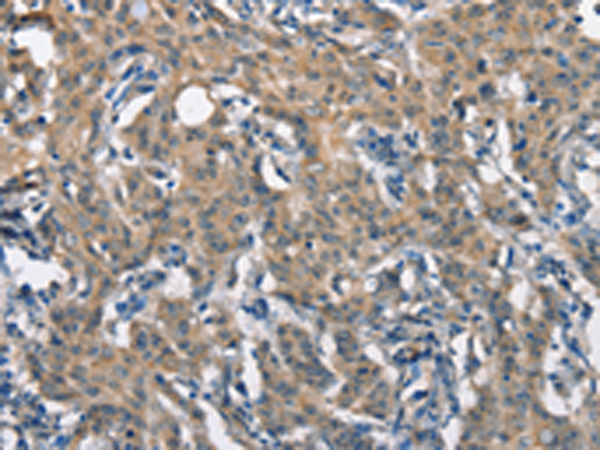
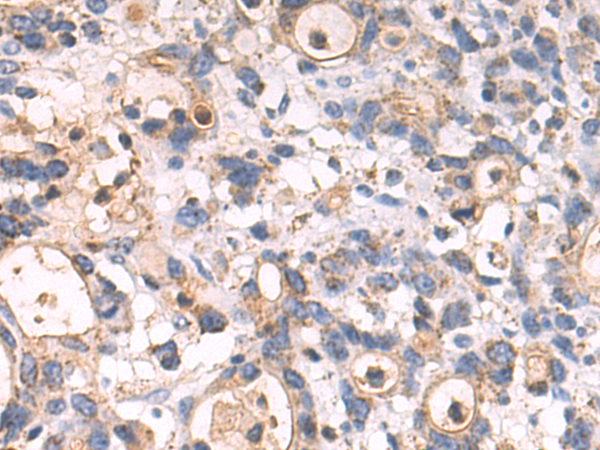

-
分类: 科研抗体货号: P07363别名: AILIM; CD278; CVID1应用: IHC反应种属: Human
-
分类: 科研抗体货号: P07340别名: H3.5; H3F3C应用: WB反应种属: Human, Mouse
-
分类: 科研抗体货号: P07322别名: A33应用: WB,IHC反应种属: Human
-
分类: 科研抗体货号: P07360别名: HSP75, HSP90L应用: WB,IHC反应种属: Human, Mouse, Rat
-
分类: 科研抗体货号: P07339别名: HIT-17应用: WB,IHC反应种属: Human, Mouse
-
分类: 科研抗体货号: P07321别名: GMR, CD116, CSF2R, SMDP4, CDw116, CSF2RX, CSF2RY, GMCSFR, CSF2RAX, CSF2RAY, GM-CSF-R-alpha应用: WB反应种属: Human
-
分类: 科研抗体货号: P07359别名: HSP105; HSP105A; HSP105B; NY-CO-25应用: WB反应种属: Human, Mouse, Rat
-
分类: 科研抗体货号: P07338别名: CLA1; SRB1; CLA-1; SR-BI; CD36L1; HDLQTL6应用: IHC反应种属: Human
-
分类: 科研抗体货号: P07320别名: CSF; GMCSF应用: WB,IHC反应种属: Human
-
分类: 科研抗体货号: P07358别名: HLD4; CPN60; GROEL; HSP60; HSP65; SPG13; HSP-60; HuCHA60应用: WB,IHC反应种属: Human, Mouse, Rat

鄂公网安备42018502007531号
鄂公网安备42018502007531号

